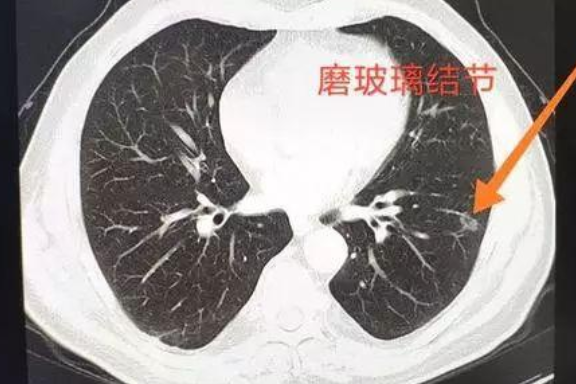
肺部磨玻璃小结节

肺部结节ct报告单

10例进展性磨玻璃结节(一):2年到浸润,最近一次ct仍诊断炎症_报告
图片尺寸737x625
"人倒霉的时候,喝水都塞牙"重庆磨玻璃结节患者的坎坷艰难医路
图片尺寸640x360
贴心医生甲状腺结节肺结节乳腺结节常见结节离癌变有多远
图片尺寸690x313
2月4日,简林的核酸检验结果呈阴性,ct显示肺部正常(之前的磨毛玻璃样
图片尺寸700x650
大家对肺部健康格外关注,尤其当首次胸部ct检查出肺结节,更加焦虑紧张
图片尺寸550x367
肺部结节的风险评估表九叔给大家整理了一份结合以上情况它们统称恶性
图片尺寸750x440
年龄24岁-65岁不等,健康体检行低剂量螺旋ct扫描,均发现肺部结节,其中
图片尺寸896x690
别被陈桂林吐黑水带偏了肺结节肺囊肿会成肺癌吗
图片尺寸690x592
近年来,肺结节成为体检报告单上的常客,让不少人十分恐慌.
图片尺寸376x725
不规则的肺结节一定是肺癌吗?pet ct=真相!_病变_玻璃_显示
图片尺寸609x528
这个肺部的结节有三种,一种是纯磨玻璃结节,就是在薄层ct片上,所出现
图片尺寸861x650
肺部结节分善恶多学科诊治识真凶
图片尺寸533x353
不规则的肺结节一定是肺癌吗?pet ct=真相!_病变_玻璃_显示
图片尺寸1080x1007
胸部ct初次发现肺部结节如何处理_体检_人群_检查
图片尺寸633x333
petct病例(8):发现肺结节不重视,造成悲剧,巫医生也很痛心_检查_进行
图片尺寸1273x821
肺部磨玻璃小结节
图片尺寸576x384
西安交大二附院结节的大小与肺结节的良恶性密切相关
图片尺寸892x627
中国肺结节人群超13亿且越来越年轻如何早期发现恶性肿瘤警惕青年群体
图片尺寸640x914
诊断需谨慎*血行播散性肺结核:均匀分布的大小,密度一致的粟粒结节2
图片尺寸554x438
(1)非肿瘤性肺结节通过ct引导下穿刺或随访观察,mtd团队不仅诊治了
图片尺寸381x302